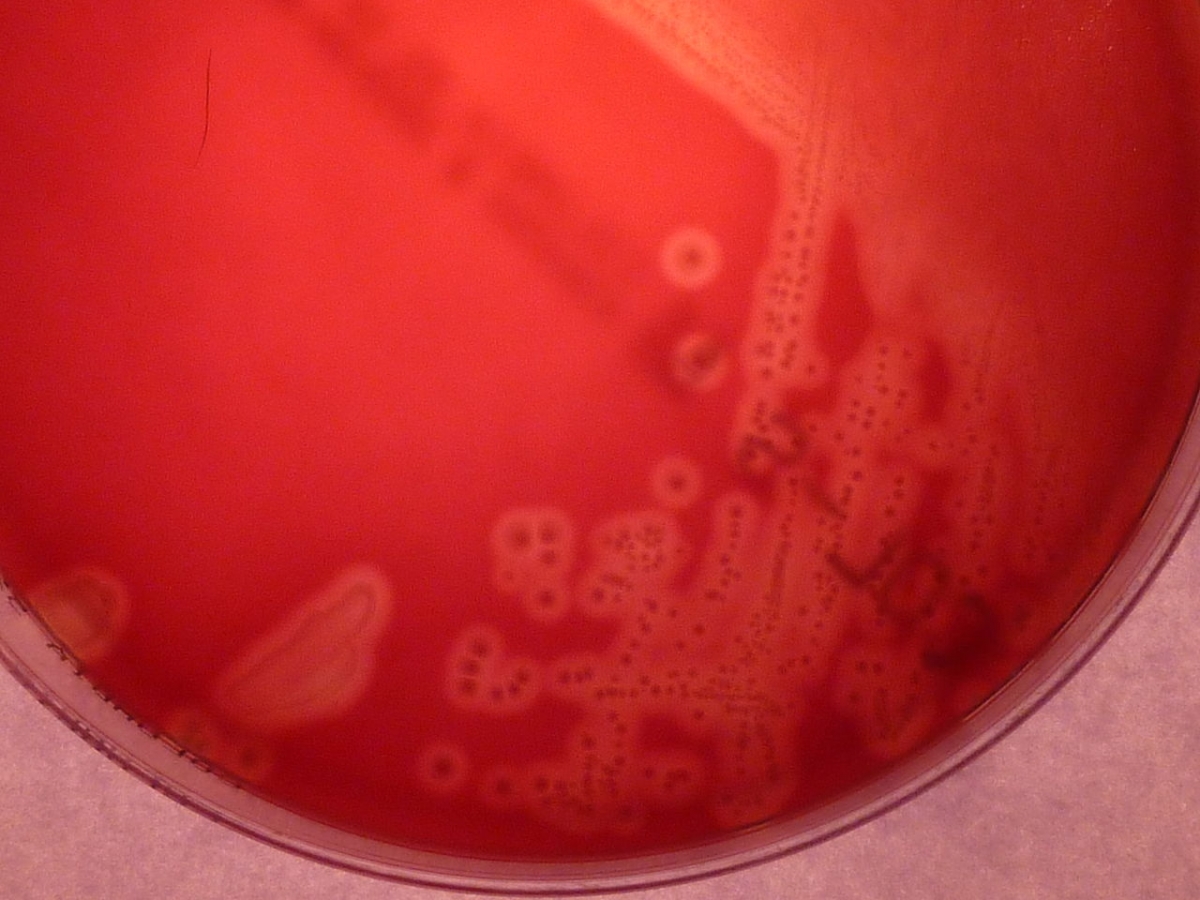

Group B Strep, also known as GBS, is an infection that can cause serious trouble for newborns if it is not addressed during labor and birth. What does GBS mean, and what do you need to know if you test positive during your prenatal appointment?
Group B Strep, or streptococcus, is a bacteria that is present in the digestive tract, rectum, and vagina of quite a few people. Normally, GBS doesn't cause any harm. But if a pregnant woman is colonized by GBS, this presents some challenges during delivery. Newborns can become seriously ill if they get GBS from their mom during the birth, but not every newborn whose mothers was GBS+ develops problems.
In the United States, all pregnant women are routinely screened for Group B Strep. This testing should be carried out five weeks or less before a woman's due date, and is done by swabbing the vagina and rectum and testing the swab in a lab. Research has shown that attempting to treat Group B Strep with antibiotics during pregnancy is not usually effective, and that the infection often returns before birth.
That is why all women who test positive for GBS receive antibiotics intravenously during their labor. These IV antibiotics reduce the risk of your baby developing GBS disease from one in 200 to one in 4000 which is an amazing difference! But, what does GBS disease do to newborns who are infected?
Early onset GBS disease can cause breathing problems, an unstable blood pressure, kidney and intestinal problems, as well as pneumonia, sepsis, and meningitis. Symptoms start showing up within hours after birth with early onset GBS disease. Late onset GBS disease is also possible. In that case, symptoms don't show up until weeks or even months later, and usually meningitis is the first symptom.









-During-Pregnancy_f_280x120.jpg)







Your thoughts on this
Loading...